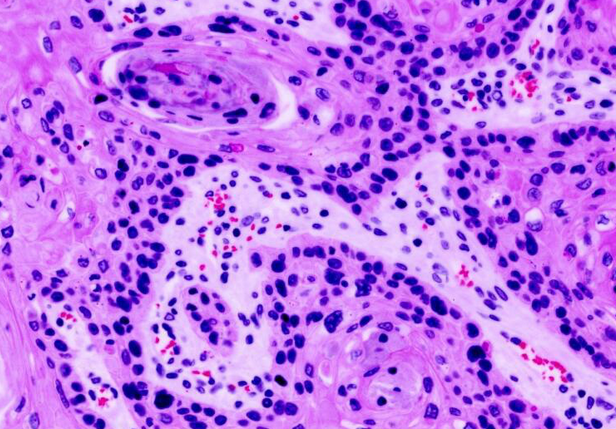
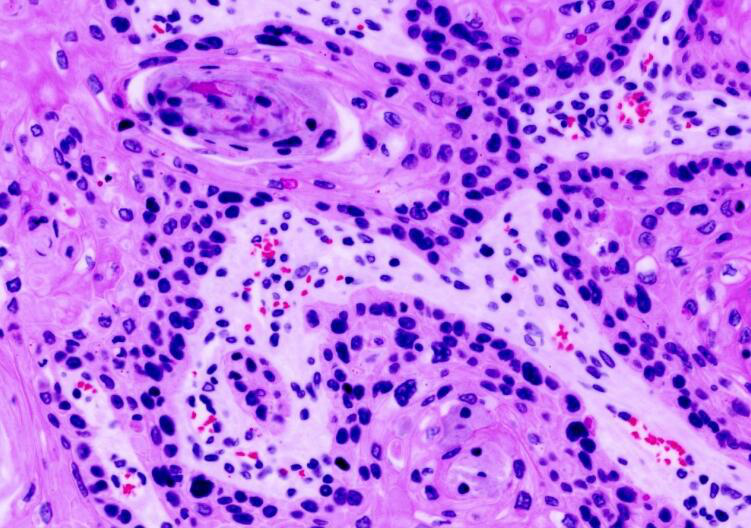

令人震撼的癌细胞特写照,发现和分析癌细胞方式将彻底改变
据每日邮报报道,通用电气公司旗下全球研究中心的科学家们正在研发一种新技术,可以让研究人员看到癌细胞的惊人细节。这套系统名为MultiOmyx,研究和治疗癌症的专家可用其分析单一组织的数十个蛋白质,从而获得更完整的肿瘤生物信息。这项技术可以让研究人员以更快的速度了解更多癌细胞信息,它将彻底改变研究人员发现和分析癌细胞的方式。
利用通用汽车公司旗下全球研究中心的MultiOmyx技术,你可以更清楚地看到癌细胞。恶性肿瘤细胞是红色的,而细胞核则是蓝色的。
但是研究人员依然需要研究样本中其他非癌症细胞,因为这些免疫细胞可能是对抗癌症的关键。图中,你可以看到蓝色和粉色污点,它们与样本中的健康细胞有明显差异。健康细胞包括浅蓝色的T细胞和粉色的巨噬细胞。
图中绿色的是纤维细胞,这是已经受到刺激而扩散的癌细胞。白色和黄色污渍显示经过肿瘤的血管。
为了更仔细地研究癌细胞功能,研究人员移除了普通癌细胞污点和纤维细胞污点,红色显示潜在的药物靶点。
与第一个样本相比,这名病人的肺部样本显得更不健康。研究人员已经用红色、绿色以及蓝色确定被用作治疗靶向的蛋白质。
在第三份肺组织样本中,癌症干细胞呈现青绿色。对于研究人员来说,确认干细胞非常重要,因为它们对化疗有很高抗性。通过查看存在多少干细胞,研究人员可以更好地评估治疗效果。
这是乳癌样本,MultiOmyx系统可被用于显示乳癌前兆。在健康乳房组织中,发现粉色和浅蓝色的蛋白质是不正常的。
左侧紫色和金色蛋白质都与乳癌有关。但在右侧,也有大量免疫细胞存在。这些免疫细胞出现在红色、绿色以及蓝色区域中。大量免疫细胞意味着,身体正竭力对抗新的肿瘤。
这是MultiOmyx系统显示的前列腺癌样本,其中癌细胞呈现紫色,而肺癌细胞则是金色的。(生物谷 Bioon.com)
相关资讯